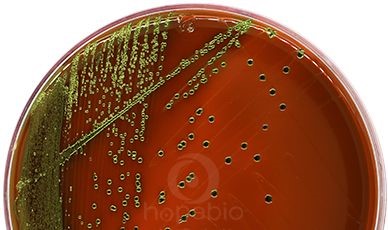

海博微信公众号
海博微信公众号
 海博天猫旗舰店
海博天猫旗舰店


 海博微信公众号
海博微信公众号
 海博天猫旗舰店
海博天猫旗舰店




检测依据:
GBT5750.2-2006生活饮用水标准检验方法水样的采集和保存
GBT5750.12-2006生活饮用水标准检验方法微生物指标
本文主要包含:
1.生活饮用水中的微生物指标
2.水样采集规则及注意事项
3.菌落总数、总大肠菌群、耐热大肠菌群、大肠埃希氏菌的测定方法
4.对所检测水样的综合分析
生活饮用水中的微生物指标
|
项目 |
单位 |
限值 |
说明 |
|
总大肠菌群 |
MPN/100ML 或 CFU/100ML |
不得检出 |
一般性污染 |
|
耐热大肠菌群 |
MPN/100ML 或 CFU/100ML |
不得检出 |
指示粪便污染 |
|
大肠埃希氏菌 |
MPN/100ML 或 CFU/100ML |
不得检出 |
指示粪便污染 |
|
菌落总数 |
CFU/100ML |
100 |
一般性污染 |
菌落总数
水样在营养琼脂上有氧环境下,37℃培养48h后,所得1ml水样所含菌落的总数。
检测意义:作为一般性污染的指标,即评价被检样品的微生物污染程度和安全性。水样菌落总数越多,说明水被微生物污染程度越严重,病原微生物存在的可能性越大,但不能说明污染的来源。
总大肠菌群
指一群在37℃培养24h能发酵乳糖,产酸产气,需氧和兼性厌氧的革兰氏阴性无芽孢杆菌。
检测意义:作为粪便污染的指标。水样总大肠菌群的含量,表明水被粪便污染的程度,而且间接地表明有肠道致病菌存在的可能。
耐热大肠菌群
指一群在44-44.5℃培养24h能发酵乳糖,产酸产气,需氧和兼性厌氧的革兰氏阴性无芽孢杆菌。我国习惯上称之为“粪大肠菌群”。
微生物指标常规检验流程图

一、水样采集
采样原则:所采集的样品具有代表性。
采样容器:不能是新的污染源:不吸收或吸附某些待测组分不与待测组分发生反应。保证从采样到分析期间样品各组分的浓度不发生改变。
微生物样品必须按一般无菌操作的基本要求采集,并保证在运送、贮存过程中不受污染。
海博生物无菌水样采集袋
自来水水样:先将自来水龙头用火焰烧灼3min灭菌再开放水龙头使水流5min(经常用水的水龙头放水1~3min)后,采集水样于无菌玻璃瓶,约占瓶容量80%,以便摇匀水样。
水源水水样:选有代表性的地点及可疑地方,一般距水面下10-15cm采集,采样后在水中改好盖子,再从水中取出。
注意事项
1.严格无菌操作。
2.做好标记:采得水样后应立即记录水样名称、地点、时间等内容。
3.从速送检。水样从采集到检验不应超过2h,在4℃下保存不应超过24h。
二、菌落总数测定
所需培养基和试剂:营养琼脂、9ml无菌生理盐水管

|

|
自来水水样检测
操作步骤:
1.以无菌操作方法用灭菌吸管吸取1mL充分混匀的水样,注入灭菌平皿中。
2.倾注约15mL已融化井冷却到45℃左右的营养琼脂培养基,并立即旋摇平皿,使水与培养基充分混匀(每次检验时应做一平行接种,同时另用一个平只倾注营养琼脂养基作为空白对照)
3.待冷却凝固后,翻转平皿,使底面向上,置于36℃±1℃培养箱内培养48h,进行菌落计数,即为水样1mL中的菌落总数。
4.培养完成后,用眼睛直接观察,必要时用放大镜检查,以防遗漏。
结果分析与报告:
计算平均菌落数,若菌落总数(cfu/ml)当检样的菌落数为1~100时,按实有数报告;大于100时,采用二位有效数字报告。
国家标准(GB5749-2006)规定生活饮用水菌落总数每毫升不得超过100个。
水源水检测
操作步骤:
1.以无操作方法吸取1mL充分混匀的水,注入盛有9mL灭菌生理盐水的试管中,混匀成1:10稀释液。
2.吸取1:10的稀释液1ml,注入盛有9mL灭菌生理盐水的试管中,混匀成1:100稀师液,按同法依次稀释成1:1000,1:1000释液等备用(如此递增稀释一次,必须更换一支1m灭菌管)。
3.然后用无菌极管取稀释的水样和2个~3个适释度的水样1mL,分别注入灭菌平皿内。之后操作同自来水水样的检验步骤。

结果分析与报告:
计算平均菌落数,首先选择平均菌落在30~300之间者进行计算。
计算方法和报告方式:

一般水源水中菌落总数与水清洁程度的关系:
|
水的类别 |
最清洁水 |
清洁水 |
不太清洁水 |
不清洁水 |
极不清洁水 |
|
菌落总数CFU/100ML |
10-100 |
100-1000 |
1000-10000 |
10000-100000 |
>100000 |
注意事项
1.菌落总数测定中,应选择合适的稀释度进行(生活饮用水,国家标准规定每毫升不得超过100个,因此以直接吸取1毫升到平板进行培养)
2.各稀释管、相应半皿做好标记。包括:水样名称、稀释度、时间、小组。
3.严格无菌操作进行水样稀释时,每一稀释度均需更换吸管。
4.倾注时,要注意营养琼脂的温度。
5.倾入琼脂后要混匀,待琼脂凝固后倒置培养。
三、总大肠菌群测定
所需培养基和试剂:乳糖蛋白胨培养液、双料乳糖蛋白胨培养液、伊红美蓝培养基
多管发酵法步骤:
初步发酵试验:采用乳糖蛋白培养液36℃±1℃培养24h观察产酸产气情况。
平板分离:对阳性管培养物,接种于伊红美蓝培养基观察菌落特征,并进行革兰氏染色和镜检。
复发酵证实试验:对典型和可疑菌落,接种于乳糖蛋白胨培养液,进行复发酵证实试验。
结果报告(MPN):根据GB5750.12-2006所附检索表报告结果。

初发酵、复发酵试验结果

大肠菌群在EMB平板上的典型特征
大肠菌群革兰氏染色镜检结果

四、耐热大肠菌群测定
所需培养基和试剂:乳糖蛋白胨培养液、EC肉汤、伊红美蓝培养基
多管发酵法步骤:
初步发酵试验:采用乳糖蛋白培养液36℃±1℃培养24h观察产酸产气情况。
耐热培养:阳性管接种在EC肉汤管中,44.5℃培养24h观察产酸产气情况。
平板培养:阳性管接种在EMB平板上,36℃±1℃培养24h。
结果报告(MPN):根据GB5750.12-2006所附检索表报告结果。

不同细菌在EC肉汤中的生长特征

五、大肠埃希氏菌测定
所需培养基和试剂:EC-MUG培养基
多管发酵法步骤:
耐热培养:将总大肠菌群初发酵中产酸或产气的管进行大肠埃希氏菌检测,接种此类试管中的液体到EC-MUG管中,在培养箱或恒温水浴中44.5℃培养24h。如使用恒温水浴,在接种后30min内进行培养,使水浴液面超过EC-MUG管的液面。
结果报告(MPN):将培养后的EC-MUG管在暗处用366nm紫外灯照射,如有蓝色荧光,则表明水样中含有大肠埃希氏菌。计算EC-MUG阳性管数,根据GB5750.12-2006所附检索表报告结果。
不同细菌在EC-MUG管中的生长特征

生活饮用水中微生物检测方法总结

生活饮用水标准检验方法——微生物指标
所需培养基汇总表
|
用途 |
产品编号 |
产品名称 |
规格 |
价格(元) |
备注 |
||
|
1.菌落总数 |
|||||||
|
总数测定 |
HB0109 |
营养琼脂(NA) |
250g |
90 |
干粉型 |
||
|
HBKP0109 |
营养琼脂 颗粒 |
250g |
120 |
颗粒型 |
|||
|
HBPM003-6 |
营养琼脂平板 |
9cm*10个 |
50 |
即用型 |
|||
|
2.1 总大肠菌群-- 多管发酵法培养基 |
|||||||
|
发酵试验 |
HB0119 |
乳糖蛋白胨培养液 |
250g |
70 |
干粉型 |
||
|
HBKP0119 |
乳糖蛋白胨培养液 颗粒 |
250g |
100 |
颗粒型 |
|||
|
HBPT009 |
乳糖蛋白胨培养液(含小导管) |
10ml*20支 |
160 |
即用型 |
|||
|
HBPT009-1 |
双料乳糖蛋白胨培养液(含小导管) |
10ml*20支 |
200 |
二倍浓缩 |
|||
|
HBPT009-3 |
乳糖蛋白胨培养液(3倍) |
5ml*20支 |
160 |
三倍浓缩 |
|||
|
分离培养 |
HB0107 |
伊红美蓝琼脂(EMB) |
250g |
110 |
干粉 |
||
|
HBKP0107 |
伊红美蓝琼脂 颗粒 |
250g |
160 |
颗粒型 |
|||
|
HBPM007 |
伊红美蓝琼脂平皿 |
9cm*10个 |
60 |
即用型 |
|||
|
镜检 |
HB8278 |
革兰氏染色液 |
5ml*8支 |
40 |
4种成份 |
||
|
2.2 总大肠菌群--滤膜法 |
|||||||
|
分离培养 |
HB0118 |
品红亚硫酸钠琼脂 |
250g |
100 |
干粉型 |
||
|
HBPM019 |
品红亚硫酸钠琼脂平皿 |
9cm*10个 |
100 |
即用型 |
|||
|
2.3总大肠菌群--酶底物法 |
|||||||
|
\ |
HB8569-2 |
MMO-MUG |
100g |
960 |
干粉型 |
||
|
3.1耐热大肠菌群--多管发酵法培养基 |
|||||||
|
发酵实验 |
HB0105 |
EC培养基 |
250g |
90 |
干粉型 |
||
|
HBKP0105 |
EC肉汤 颗粒 |
250g |
125 |
颗粒型 |
|||
|
HBPT020-1 |
EC肉汤(含小导管) |
10ml*20支 |
160 |
即用型 |
|||
|
确证 |
伊红美蓝琼脂 (相关信息见上表) |
||||||
|
3.2 耐热大肠菌群-滤膜法 |
|||||||
|
分离 |
HB0154 |
MFC琼脂 |
250g |
160 |
干粉型 |
||
|
确证 |
EC培养基(相关信息见上表) |
||||||
|
4.1大肠埃希氏菌--多管发酵法 |
|||||||
|
发酵实验 |
HB8559-1 |
EC-MUG培养基 |
100g |
360 |
干粉型 |
||
|
HBPT8559-1 |
EC-MUG培养基管 |
10ml*20支 |
200 |
即用型 |
|||
|
4.2大肠埃希氏菌--滤膜法 |
|||||||
|
分离培养 |
HB8558-1 |
NA-MUG |
100g |
660 |
干粉型 |
||
|
4.3大肠埃希氏菌--酶底物法 |
|||||||
|
\ |
HB8569-2 |
MMO-MUG |
100g |
960 |
干粉型 |
||
|
|
|
|
|
|
|
||
|
采水袋 |
CYD004 |
无菌水样采集袋 |
100只/箱 |
500 |
\ |
||
|
CYD005 |
无菌水样采集袋(含0.4mg硫代硫酸钠) |
100只/箱 |
520 |
\ |
|||




